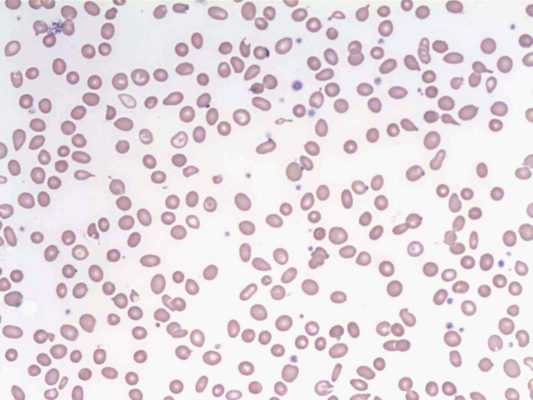
Лечение синдрома Юргенса в Израиле

Синдром Юргенса (Jurgens) - синонимы, авторы, клиника
Добавил пользователь Валентин П. Обновлено: 11.12.2025
Синдром Юргенса - патология, передающаяся по наследству, которая проявляется беспричинными кровотечениями и спонтанным образованием подкожных гематом. На более поздних стадиях случаются кровоизлияния во внутренние органы и суставы. Чтобы нормализовать состояние больного, специалисты клиники Ассута применяют уникальные методы консервативного лечения и назначают лекарственные препараты последней генерации. Лечение синдрома Юргенса в Израиле в Ассуте - это надежная стабилизация состояния здоровья и предотвращение обширных кровотечений Узнать больше…
У больных с данной патологией присутствует врожденная нехватка особого белка, отвечающего за качество свертываемости крови (фактора Виллебранда). Основные симптомы заболевания - подкожные геморрагии или гематомы, которые образуются даже в результате небольших травм, желудочно-кишечные, носовые и внутричерепные кровотечения. У женщин могут случаться маточные кровотечения и анемизирующие меноррагии.
Диагностика и лечение

Лечебный протокол для каждого отдельного пациента составляется в зависимости от типа заболевания, который был диагностирован. Всего существует 3 типа синдрома Юргенса . Первый является самым простым, проявляющийся редкими кровотечениями, и хорошо поддающийся медикаментозной терапии, при втором типе возникают подкожные гематомы. Третий тип - наиболее опасный, так как в крови больного полностью отсутствуют факторы свертываемости крови.
Залог проведения успешной терапии синдрома Юргенса - точность постановки диагноза. Потому в процессе подбора методов дифференциальной диагностики особое внимание уделяется назначению молекулярных и иммунофлуоресцентных проверок. Для беременных женщин обязательно пренатальное обследование и специальный анализ крови.
Основные методы обследования:
- Коагулограмма - расширенное изучение элементов, содержащихся в крови, в частности, тромбоцитов, участвующих в свертываемости крови
- Определение протомбированного индекса - измерение скорости свертываемости крови
- Анализ активированного частичного тромбопластиновго времени - наиболее информативная проверка, показывающая эффективность свертываемости, выявляющая антитела, препятствующие коагуляции и дефицит необходимых элементов
- Анализ плазмы - исследование, изучающее качественный и количественный показатель свертываемости в крови больного
- Иммуноэлектрофорез - специальный тест, предназначенный для определения размера мультимера фактора свертываемости в сыворотке крови и тромбоцитах.
Лечение синдрома Юргенса в клинике Ассута Тель-Авив составляется на основе полученной в результате диагностики информации. В первую очередь, врач подбирает эффективные способы нормализации гемостаза, а затем назначает дополнительные терапевтические мероприятия:
- Лекарственная терапия отличается высокой эффективностью на первых этапах развития заболевания. Один из наиболее действенных препаратов - «Деспомопрессин», искусственный аналог препарата «Вазопрессин», который активирует способность организма самостоятельно продуцировать факторы свертываемости крови. Если возникает необходимость экстренной остановки кровотечения, применяются тромбиновые или фибриновые лекарственные средства. Узнать больше…
- Трансфузионная (заместительная) терапия предназначена для насыщения крови больного факторами свертываемости. В процессе ее проведения используются криопреципитаты, антигемофильная плазма и другие гемопрепараты.
- Пересадка костного мозга проводится тогда, когда заболевание представляет угрозу для жизни пациента. По отзывам о лечении синдрома Юргенса в больнице Ассута, данный лечебный метод эффективен в подавляющем большинстве случаев.
Ориентировочная программа
- Консультация генетика и гематолога
- Аппаратные и лабораторные исследования
- Составление персонального плана лечения
- Прохождение терапевтических мероприятий
- Наблюдение и контроль состояния здоровья
Вопросы пациентов
1. Реально ли с помощью лекарств вылечить синдром Юргенса 2-А типа?
Лекарственная терапия - дополнительный метод лечения. При 2-м типе заболевания отличных результатов позволяет достичь заместительная терапия, подразумевающая использование плазменных концентратов с высоким содержанием фактора 8 (Виллебранда). Для повышения эффективности такого лечения иногда назначают «Десмопрессин» и другие препараты.
2. Моей сестре делали переливание крови при тромбоцитопатии. Поможет ли этот способ лечения при моем диагнозе «синдром Юргенса»?
Переливание тромбоцитарной массы борется с дисфункциями тромбоцитов, поэтому оно действенно при тромбоцитопатии. Данная патология может развиваться как осложнение синдрома Юргенса, поэтому главная задача - выявить первопричину болезни и устранить ее проявления, с чем способ переливания крови здесь не справится, поскольку дисфункция тромбоцитов при синдроме Юргенса - явление вторичное.
3. Как при синдроме Юргенса предотвратить кровотечения?
После прохождения курса терапии лечащий врач составляет перечень индивидуальных рекомендаций для пациента, что входит в стоимость лечения синдрома Юргенса в центре Ассута в Израиле. Во-первых, необходимо заниматься гимнастикой для поддержания тела в хорошей форме, чтобы организм мог противостоять бытовым травмам. Во-вторых, не следует заниматься травматичными, опасными видами спорта, избегать приема лекарственных средств, разжижающих кровь. В-третьих, больным с тяжелыми формами болезни нужно иметь в домашней аптечке препараты на основе факторов свертываемости крови, уметь самостоятельно делать инъекции.
Преимущества лечения в Ассуте
- Опытные квалифицированные гематологи
- Эффективно продуманная терапевтическая программа
- Прозрачные цены лечения синдрома Юргенса
Позвоните в центр Assuta Tel-Aviv - узнайте, когда именно вас смогут госпитализировать для обследования и качественного лечения
Что такое Синдром Виллебранда-Юргенса? Причины, симптомы и медицинская помощь больным с синдромом Виллебранда-Юргенса
Синдром Виллебранда-Юргенса (конституционная тромбопатия) - самое распространённое врождённое нарушение свёртываемости крови. Заболевание также часто называют «наследственной антигемофилией». Картина заболевания, действительно, очень схожа с гемофилией. При ранениях кровотечение продолжается дольше обычного. Подкожно образуются гематомы.
Известно, что в образовании тромба, закрывающего рану, участвуют тромбоциты. Однако, без участия специфического белка (фактора Виллебранда) свёртываемость нарушается из-за невозможности тромбоцитов прилепиться к стенкам сосудов. В дополнение к этому, заболевание вызывает проницаемость и хрупкость сосудов. У пациентов с синдромом Виллебранда-Юргенса нарушена цепь гомеостаза, поэтому опасность любых кровотечений очень велика. Особенно большому риску подвержены больные женщины, поскольку менструации у них носят затяжной характер — вплоть до истощения. Вместе с тем, известны случаи, когда беременные больные с синдромом Виллебранда-Юргенса успешно вынашивают ребёнка, и роды проходят без осложнений.
Также замечено, что течение болезни меняется с возрастом. В некоторых случаях происходит полное излечение или степень нарушений заметно снижается.
2. Типы заболевания в зависимости от тяжести болезни
Тяжесть заболевания классифицируется по типам:
- 1 тип. Самая распространённая и лёгкая форма. Снижение свёртываемости крови незначительное. Больной может не подозревать о наличии синдрома. Фактор Виллебранда-Юргенса присутствует в крови, но в недостаточной концентрации.
- 2 тип. Фактор Виллебранда-Юргенса в крови есть, но не работает. Форма более редкая, но и более опасная. Наследуется в ряде случаев, — при определенном сочетании генетических характеристик родителей. Проявляется незначительными кровотечениями без видимых предпосылок.
- 3 тип. Лишь у 5% больных фактор Виллебранда-Юргенса отсутствует полностью. Серьёзная опасность кровотечений, анемий и осложнений при операциях.
Чаще всего синдром Виллебранда-Юргенса — врождённая патология. Приобретается заболевание на фоне некоторых других состояний и нарушений.
Поскольку в основе синдрома Виллебранда-Юргенса — нарушение свёртываемости, то кровь может появляться там, где у здорового человека кровотечений быть не должно. Наиболее часто наблюдаются:
- носовые кровотечения;
- менструальные кровотечения у женщин;
- кровь в моче;
- подкожные гематомы;
- кровоточивость слизистых рта;
- тёмный стул (с примесью крови);
- суставные кровоизлияния в результате движения.
Даже при 1 типе заболевания пациент при посещении любого врача должен сообщить ему о своём диагнозе, поскольку многие манипуляция, исследования и процедуры связаны с микротравмами, неопасными для здоровых людей. Состояние пациента должно учитываться при назначениях и выборе ему той или иной схемы лечения.
3. Диагностика болезни
Диагностика при подозрении на синдром Виллебранда-Юргенса включает измерение времени свёртываемости крови, оценку активности фактора Виллебранда, генетическое исследование.
4. Лечение синдрома Виллебранда-Юргенса
Специфического лечения этого заболевания не существует. Медицинская помощь направлена обычно на остановку возникших кровотечений. В случае необходимости хирургического лечения, принимаются меры для профилактики кровотечений (используются препараты плазмы с высоким содержанием фактора Виллебранда, десмопрессин, аминокапроновая кислота). В случае тяжёлых форм заболевания, когда велика опасность кровотечений даже при бытовых травмах и ушибах, назначают препараты, препятствующие разрушению тромбов после их образования. В качестве экстренной помощи используется фибриновый клей или промбиновый порошок, помогающие остановить кровотечение из раны.
Больные должны знать и избегать приёма препаратов, побочным эффектом которых является снижение свертываемости крови (гепарин, аспирин, ибупрофен, напроксен, лекарства, содержащие салицилаты). Больные с тяжёлыми формами должны уметь сделать себе инъекцию факторов свёртывания крови. Также необходимо знать и определять признаки скрытых кровотечений. Для снижения бытового травматизма нужно следить за весом, поддерживать хорошую физическую форму, избегая при этом опасных видов спорта.
Заболевания Жалобы и симптомы- Высокая температура тела
- Иммунитет снижен
- Боли различной локализации
- Резкое снижение или набор веса
- Плохая работы желудка тракта
- Частые ОРЗ, ОРВИ
- Слабость, головокружение, недомогания
Если вы обнаружили у себя подобные симптомы, возможно, это сигнал заболевания, поэтому рекомендуем проконсультироваться с нашим специалистом.
Диагностика- ЭКГ (электрокардиограмма)
- Общий анализ крови
- Биохимический анализ крови
- Общий анализ мочи
- Пульсоксиметрия
- Консультация терапевта - от 1500 р.
- Биохимический анализ крови (стандартная, 10 показателей) - 2470 р.
- Биохимический анализ крови (расширенаяая, 14 показателей) - 3565 р.
- Общий анализ крови - 675 р.
- ЭКГ (электрокардиография) - 1500 р.
- Общий анализ мочи - 320 р.
- Пульсоксиметрия - 500 р.
Мы стараемся оперативно обновлять данные по ценам, но, во избежание недоразумений, просьба уточнять цены в клинике.
Данный прайс-лист не является офертой. Медицинские услуги предоставляются на основании договора.
Newmed
Почему пациенты из стран СНГ
выбирают «НьюМед Центр»?

"NewMed Center Israel" - преимущества
- общаемся на русском
- консультируем бесплатно
- подбираем лучшего узкопрофильного специалиста
- бронируем билеты
- бронируем проживание
- оформляем приглашение
- осуществляем трансфер
- работаем без предоплаты
- осуществляем оплату в кассу клиник по ценам клиник
- организовываем экскурсии
Лечение синдрома Юргенса в Израиле
Развитие синдрома Юргенса - это патологический процесс, который связан с наследственными причинами. Обуславливается он недостаточностью фактора Виллебранда (vWF) - специфического белка, который защищает фактор VIII свертываемости крови от протеолиза, участвует в адгезии тромбоцитов при формировании сгустка. Помимо снижения уровня фактора VIII в плазме, у больных наблюдается патологическая дилятация и повышенная проницаемость сосудов. Основное проявление заболевания - спонтанные кровотечения, как при гемофилии. В некоторых источниках синдром Юргенса называют псевдогемофилией. Специалисты компании NewMed Center рекомендуют пройти лечение синдрома Юргенса в Израиле по оптимальной программе.
Инновационные методы обследования синдрома Юргенса в Израиле
Для подтверждения диагноза, определения типа заболевания пациенту назначается развернутое исследование крови. Первые данные о наличии нарушений дает коагулограмма, которая фиксирует период свертываемости, содержание тромбоцитов. Ключевой показатель, который получают в ходе проведения данной проверки, - это протромбиновый индекс. Если он менее 95-105%, это подтверждает наличие гипокоагуляции, то есть повышенной вероятности геморрагии.
Диагностика синдрома Юргенса в больницах предусматривает также исследование на активированное частичное тромбопластиновое время (сокращенно АЧТВ). С его помощью анализируется механизм коагуляции, выявляется неэффективность или недостаточность участвующих в нем компонентов. Для анализа количества и активности фактора vWF используется анализ плазмы и иммуноэлектрофорез.
Новейшие методы лечения синдрома Юргенса в Израиле
Решающее значение в разработке программы лечения синдрома Юргенса в клиниках имеет тип заболевания. От этого зависит, что необходимо корректировать: полное отсутствие фактора Виллебранда, его дефицит либо нарушение функции. По отзывам о лечении синдрома Юргенса в Израиле, иногда специалистам приходится осуществлять экстренные мероприятия по устранению кровотечений при открытых повреждениях - на рану наносится фибриновый клей либо тромбиновый порошок.
В лечении можно выделить два направления: незаместительная и заместительная терапия. Незаместительное (медикаментозное) лечение предусматривает назначение десмопрессина - препарата, который стимулирует высвобождение фактора vWF из клеток организма. Перед хирургическими вмешательствами пациентам с этим заболеванием назначают транексамовую и аминокапроновую кислоту для стабилизации сгустков, которые образуются тромбоцитами. При мелких кровотечениях используются препараты местного действия, например - тромбин-JMI.
Заместительная терапия представляет собой трансфузию препаратов крови с фактором vWF. При синдроме Юргенса введение криопреципитата либо свежей донорской плазмы обеспечивает более значительное и продолжительное повышение активности фактора VIII, нежели при гемофилии А.
Ответы докторов на вопросы пациентов
- Если поставлен диагноз синдром Юргенса тип 1, что это значит?
Тип 1 данного заболевания наименее опасен и наиболее распространен. Речь идет о недостаточности фактора Виллебранда (vWF), которая поддается медикаментозной коррекции.
- Как снизить риск кровотечений при наличии болезни?
Стоимость лечения синдрома Юргенса в Израиле включает разработку для пациента рекомендаций касательно способа жизни. Больным не следует заниматься опасными видами спорта, но, в то же время, поддерживать хорошую физическую форму во избежание бытового травматизма. При наличии тяжелых форм заболевания необходимо иметь дома препараты, содержащие факторы свертываемости крови, и уметь самостоятельно делать себе их инъекции. Серьезную опасность для больных представляет прием лекарств, снижающих свертываемость крови, к примеру - аспирина, гепарина, ибупрофена.
Пройдите лечение в Израиле синдрома Юргенса по цене, которая вас устроит!
Юргенса синдром
1. Малая медицинская энциклопедия. — М.: Медицинская энциклопедия. 1991—96 гг. 2. Первая медицинская помощь. — М.: Большая Российская Энциклопедия. 1994 г. 3. Энциклопедический словарь медицинских терминов. — М.: Советская энциклопедия. — 1982—1984 гг .
Смотреть что такое "Юргенса синдром" в других словарях:
Юргенса синдром — (R. Jurgens, 1898 1961, нем. гематолог) см. Ангиогемофилия … Большой медицинский словарь
БОЛЕЗНЬ ФОН ВИМЕБРАНДА — мед. Болезнь фон Вимебранда (*193400, 12pter pl2, дефекты генов VWF, F8VWF, ЗД; • 277480, р, типы ПС, III; • 177820, дефект рецептора ффВ, см. также Синдром Бернара Сульё) врождённое отсутствие мультимерных форм фактора VIII фон Впмебранда… … Справочник по болезням
ангиогемофилия — (angiohaemophilia; ангио + гемофилия; син.: Виллебранда болезнь, Виллебранда Юргенса конституциональная тромбопатия, гемофилия сосудистая, капилляропатия геморрагическая, псевдогемофилия сосудистая, пурпура атромбопеническая, пурпура… … Большой медицинский словарь
Ангиогемофилия — I Ангиогемофилия (греч. angeion сосуд + Гемофилия) наследственная болезнь, характеризующаяся резким увеличением времени кровотечения и понижением активности или содержания VIII фактора свертывания крови (тромбопластического фактора плазмы) при… … Медицинская энциклопедия
Болезнь фон Виллебранда — МКБ 10 D68.0 МКБ 9 286.4 OMIM 193400 … Википедия
Болезнь Виллебранда — МКБ 10 D68.068.0 МКБ 9 286.4286.4 OMIM … Википедия
ВВГБТАТНВЦ-АЯ — HEt BHiH С И С ГОД 4 U ВЕГЕТАТИВНАЯ НЕГПНАН CIH TFMA III й*гл*. 4411^1. Jinn РИ"И рягцхш^чпт* dj ^LbH [ljii vmrlu+W 0*1 WII» *П* ЬмК Риг, П. С«ема хала волокон симпатической системы (вариант no Toldt y н MQltcr y), 1 нс, 12,… … Большая медицинская энциклопедия
АМБЕН — Действующее вещество ›› Аминометилбензойная кислота (Aminomethylbenzoic acid) Латинское название Ambenum АТХ: ›› B02AA03 Аминометилбензойная кислота Фармакологическая группа: Ингибиторы фибринолиза Нозологическая классификация (МКБ 10) ›› C95… … Словарь медицинских препаратов
Service-Med
Почему пациенты из Москвы
выбирают «ServiceMed»?

«ServiceMed» - координационный центр в Москве лучших клиник Израиля
Лечение синдрома Юргенса в Москве

Синдром Юргенса относится к заболеваниям, переходящим по наследству. Проявляется он редкими спонтанными кровотечениями и гематомами, а в более тяжелых случаях - обширными кровоизлияниями в суставы или внутренние органы. В данном случае, чем своевременнее будет начато лечение, тем быстрее нормализуется состояние такого больного. Сделать это лучше в Израиле, где в настоящее время с этой проблемой достаточно успешно борются местные врачи. Сориентироваться во множестве предложений, получить консультацию израильского гематолога и подобрать наиболее подходящую клинику вам помогут сотрудники компании ServiceMed, в центре лечения синдрома Юргенса в Москве. Узнать больше…
У пациентов с таким синдромом обычно диагностируют дефицит особого белка (фактора Виллебранда), который отвечает за свертывание крови. Для таких больных свойственны сильные кровотечения даже при незначительном травмировании. Особо болезнь не щадит женщин, которые страдают от анемизирующих меноррагий и маточных кровотечений. Лечение синдрома Юргенса в больницах Москвы мы не производим, после консультации наши клиенты направляются для прохождения целевой терапии в одну из израильских клиник.
Эффективность лечения синдрома Юргенса напрямую зависит от точности поставленного диагноза, потому израильские врачи уделяют большое значение дифференциальной диагностике, которая начинается со скрининговых тестов и включает в себя:
- Коагулограмму. С ее помощью комплексно исследуется кровь, время ее свертываемости и оценивается уровень тромбоцитов
- Протромбиновый индекс. Показывает, насколько вероятна склонность к кровотечениям. Так, если этот индекс ниже нормы, то это говорит о гипокоагуляции (пониженной свертываемости крови)
- Анализ на АЧТВ. Один из самых точных тестов, который дает понимание о том, насколько эффективен механизм свертывания. Также он позволяет выявить дефицит специфических факторов и антител, препятствующих процессу коагуляции
- Анализ плазмы крови. Определяет не только качество фактора фон Виллебранда, но и его количественные показатели
- Иммуноэлектрофорез. Благодаря ему проводится оценка величины факторов в сыворотке крови и тромбоцитах, с определением их активности.
В общий расчет стоимости лечения синдрома Юргенса в Москве диагностика вводится обязательно, однако израильские врачи ее нередко корректируют. Будет ли цена снижена или увеличена — зависит от числа проведенных тестовых исследований.
Современные методы лечения
Способ и объем необходимых лечебных мероприятий определяется по результатам проведенного обследования в клинике лечения синдрома Юргенса в Москве, с дальнейшей корректировкой программы в Израиле. Первоочередными действиями врачей по нормализации гемостаза являются:
- Медикаментозная терапия. Достаточно эффективна при лечении начальной стадии синдрома. Хорошие результаты показывает прием препарата десмопрессин (аналог вазопрессина), который существенно усиливает выработку фактора свертываемости
- Трансфузионная терапия. Ее выполняют с использованием криопреципитата, антигемофильной плазмы и других препаратов крови, в составе которых есть фактор Виллебранда. Подобная терапия активизируют выработку собственного фактора и позволяет нормализовать состояние больного. Цена на лечение синдрома Юргенса в Москве и Израиле зависит от вида препарата и количества проведенных процедур.
При угрожающем жизни пациента состоянии гематологи прибегают к пересадке костного мозга. Своевременность операции гарантирует наличие в Израиле обширной базы донорских трансплантатов. О том, насколько результативны израильские методики, вы можете узнать на сайте ServiceMed, прочитав отзывы о лечении синдрома Юргенса в Москве.
Преимущества лечения с ServiceMed
- Известные всему миру гематологи
- Результативные препараты новой генерации
- Высокое качество проводимых трансплантаций
- Доступные цены на лечение синдрома.
С ServiceMed вам гарантирован позитивный результат лечения синдрома Юргенса!
Специалист с мировым именем в области онкогематологии, автор множества научных работ, участник международных конференций и член профессиональных ассоциаций в Израиле и других странах
Читайте также:
